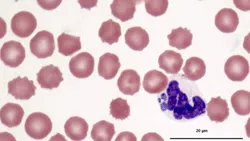
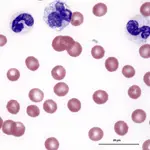

What Your Hematology Analyzer Can't Tell You

Collection of a peripheral blood sample allows a practitioner the opportunity to perform a complete blood count (CBC), which includes automated analysis of the blood and microscopic evaluation of the peripheral blood smear.
The peripheral blood smear (blood film) not only confirms and refines numeric data reported by the hematology analyzer, but also adds useful information when evaluated by a trained microscopist:
Red blood cell (RBC) quantity (RBC count, hematocrit, hemoglobin)
RBC indices (mean cell volume, mean cell hemoglobin concentration, RBC distribution width)
White blood cell (WBC) count
WBC differential
Platelet count
Platelet indices (mean platelet volume)
Each of the following cases highlight different reasons why it remains important for trained personnel to examine blood films even when an advanced, automated hematology analyzer is used to obtain data.
CBC = complete blood count; RBC = red blood cell; WBC = white blood cell
Case 1: Lameness & Pyrexia
A 10-month-old, female bloodhound presented for acute onset shifting leg lameness and pyrexia (104° F/40° C). Table 1 provides blood analysis results; Figures 1 through 3 show the blood films.
Figure 1: Intragranulocytic, dark blue, stippled, irregularly shaped morula adjacent to segmented neutrophil nucleus; platelets are not visible. (_Wright-Giemsa, 100×)_

Figure 2: Intragranulocytic, dark blue, stippled, crescent-shaped morula adjacent to the segmented neutrophil nucleus. (_Wright-Giemsa, 100×)_
Figure 3: Intragranulocytic, dark blue, stippled, round morula

surrounded by the segmented neutrophil nucleus. (_Wright-Giemsa, 100×)_
ASK YOURSELF…
Is the patient truly thrombocytopenic as suggested by the automated CBC?
Is the cause of clinical signs evident in the blood film?
Case 2: Acute Onset of Congestive Heart Failure
A 3.5-year-old, castrated male French bulldog was diagnosed with acute onset congestive heart failure. Table 1 provides blood analysis results; Figures 4 and 5 show the blood films.
Figure 4: Low-power scanning reveals 2 microfilariae. Leukocytes are moderately increased with numerous band neutrophils present along with a lesser number of segmented neutrophils, 2 monocytes, and 1 eosinophil. Erythrocyte density is moderately decreased consistent with numeric RBC data; 1+ anisocytosis and 1+ polychromasia are also present. Platelets are mildly decreased, which is consistent with thrombocytopenia. (_Wright-Giemsa, 20×)_

Figure 5: Closer magnification of Figure 4 reveals 2+ toxicity in many band neutrophils; 1 band is 3+ toxic (far right). Erythrocyte density is moderately reduced with 1+ anisocytosis, 1+ polychromasia, and a single nucleated RBC (upper left). Platelets are mildly decreased and there are 2 RBC fragments, including a schistocyte (left). (_Wright-Giemsa, 50×)_
ASK YOURSELF…
Are the erythrocyte and neutrophil morphologies abnormal?
Are the automated leukocyte count and leukocyte differential accurate?
Is the patient truly thrombocytopenic?
Is the cause of clinical signs suggested by the blood films?
Case 3: Prior History of Leukemia & Chemotherapy
An 8-year-old, castrated male mixed-breed dog with a prior history of leukemia and chemotherapy was presented for a follow-up CBC. Table 1 provides blood analysis results; Figures 6 and 7 show the blood films.

Figure 6. In dogs, the predominant leukocyte is the neutrophil. However, in this case, large lymphoblasts predominate. Pale staining, oval nucleoli are visible in 2 of the lymphoblasts (lower left cell, lower right cell). Erythrocyte density is moderately reduced and numerous intraerythrocytic piroplasms are present. (Wright-Giemsa, 100×)

Figure 7. Figure 6 magnified to show intraerythrocytic piroplasms consistent with Babesia canis. Immunosuppressive chemotherapy likely unmasked a latent B canis infection, which caused parasitemia and contributed to this dog’s anemia. (Wright-Giemsa, 100×)
ASK YOURSELF…
Although the total leukocyte count is normal, is the patient out of remission?
Is the automated leukocyte differential accurate?
What are the intraerythrocytic inclusions?
Purpose of Blood Film Evaluation as Part of a Full CBC1. Confirm & refine numeric data reported by hematology analyzer • RBC quantity: RBC count, hematocrit, hemoglobin • RBC indices: MCV, MCHC, RDW • WBC count • WBC differential • Platelet count • Platelet indices: MPV2. Add useful information that only a trained microscopist can provide • RBC morphology: Size, shape, color, & inclusions • WBC morphology: Detect changes consistent with inflammatory, neoplastic, or hereditary diseases • Platelet morphology: Size & inclusions • Detect infectious diseases
CBC = complete blood count; MCHC = mean cell hemoglobin concentration; MCV = mean cell volume; MPV = mean platelet volume; nRBC = nucleated red blood cell; RBC = red blood cell; RDW = red blood cell distribution width; WBC = white blood cell
Case 1: Lameness & Pyrexia
Diagnosis: Doxycycline-responsive tick-borne disease (Ehrlichia ewingii or Anaplasma phagocytophilum)

Interpretation & DiscussionThe blood film not only verified the thrombocytopenia shown by the hematology analyzer, but also revealed numerous morulae within neutrophils (Figure 8), which cannot be detected by analyzers. This important diagnostic finding, combined with the intragranulocytic morulae found in the patient’s synovial fluid (Figure 9), explained the patient’s clinical signs and provided a diagnosis. On a side note, at the time of this case presentation, only the SNAP 3Dx test (idexx.com) was available, which was negative.

Figure 8: Figure 1 magnified to show the intragranulocytic morula consistent with Ehrlichia ewingii or Anaplasma phagocytophilum.
Figure 9: Synovial fluid with neutrophilic inflammation and intragranulocytic morula; 2 segmented neutrophils are present on a granular eosinophilic background consistent with mucin from synovial fluid. One neutrophil (left) contains a navy blue, stippled, circular morula.
Did you answer...
The number of platelets in the blood film is reduced and consistent with the thrombocytopenia reported by the hematology analyzer.
Intragranulocytic morulae are likely the cause of the patient’s acute pyrexia and lameness.
Case 2: Acute Onset of Congestive Heart Failure
Diagnosis: Caval syndrome associated with severe inflammation and fragmentation hemolysis
Interpretation & DiscussionExamination of the blood film in this case revealed several significant findings that cannot be detected by hematology analyzers (Table 2):
Data from the hematology analyzer was, depending on the cell line, verified, refined, or corrected.
The underlying etiology of the patient’s congestive heart failure was indicated (Figure 10).
Abnormalities suggestive of disseminated intravascular coagulation were found.

Toxic Change. Hematology analyzers are not able to detect toxic change but it can be seen in the blood film (Figure 11). The toxic change occurred from severe inflammation with accelerated neutrophil production by the marrow or the direct effect of circulating bacterial endotoxins on differentiating neutrophils.
Figure 10: Closer magnification of Figures 4 and 5 reveals a microfilaria surrounded by band neutrophils with 1+ to 2+ toxic change.
Figure 11: A reactive monocyte with increased cytoplasmic basophilia and punctate vacuolation is present between two 2+ to 3+ toxic band neutrophils. The band neutrophil on the left has a U-shaped nucleus; the band neutrophil on the right has an S-shaped nucleus and a few small Döhle bodies. The erythrocyte density is moderately decreased; there is 1+ anisocytosis. There is a single small platelet (above & right of center).
Left Shift. Hematology analyzers do not distinguish mature, segmented neutrophils from more immature (left-shifted) cells, such as band neutrophils and metamyelocytes (Figure 11). This dog had a significant regenerative left shift, suggesting inflammation of sufficient severity that the marrow must release immature, slightly less functional neutrophils (ie, bands and metamyelocytes) in order to satisfy the requirements of inflamed tissues. Evaluation of the peripheral blood film refined the neutrophil data obtained from the hematology analyzer, allowing identification of the left shift.
Platelets. The hematology analyzer’s platelet count was below the reference interval. The blood film revealed a reduced number of platelets and absence of significant platelet clumping, confirming thrombocytopenia. Falsely decreased platelet counts due to clumping occur so commonly that it is essential to always verify a low automated platelet count by examining a blood film (Figure 12).
Nucleated Red Blood Cells. Nucleated red blood cells (nRBCs) are counted by hematology analyzers as nucleated cells that are not distinguished from leukocytes, so nRBCs are lumped into the total leukocyte count. When there are more than 5 nRBCs per 100 WBCs, a correction formula can be used to adjust the automated leukocyte count down to a more accurate value:
(Uncorrected WBC count per mcL × 100 / nRBCs per 100 WBCs + 100)= Corrected WBC count per mcL

Figure 12: In this blood film, a few platelet clumps are present, but the platelets trapped within the clumps are not counted by the hematology analyzer.
DIC = disseminated intravascular coagulation; nRBC = nucleated red blood cell; WBC = white blood cell
This correction will also adjust inaccurately elevated absolute counts of each leukocyte type in the leukocyte differential. In addition to the nRBCs, the dog also had other findings consistent with a regenerative anemia, including polychromasia and anisocytosis.
Microfilariae. Numerous microfilariae, which cannot be detected by hematology analyzers, were observed on the blood film and suggested the cause of the dog’s congestive heart failure. Subsequent echocardiography revealed caval syndrome, a condition where a mass of worms in the right heart disrupts normal blood flow and can cause fragmentation hemolysis, which can, in turn, incite disseminated intravascular coagulation (DIC). The few schistocytes observed in the blood film indicated mild fragmentation hemolysis. Schistocytes found in tandem with anemia and confirmed thrombocytopenia also indicated development of DIC.
Did you answer…
The erythrocytes show increased polychromasia and anisocytosis, and there are some nRBCs and schistocytes. The neutrophils are 2+ to 3+ toxic and left-shifted, with many band neutrophils in circulation.
nRBCs are counted with other nucleated cells by hematology analyzers and included in the total leukocyte count, causing a falsely increased total leukocyte count if there are > 5 nRBCs/100 WBCs. Band neutrophils and further left-shifted neutrophils are usually counted as mature, segmented neutrophils by hematology analyzers.
The number of platelets in the blood film is reduced, consistent with the thrombocytopenia reported by the hematology analyzer. Concurrent thrombocytopenia, anemia, and poikilocytosis due to schistocytes raise concern for possible underlying DIC.
Circulating microfilariae suggest heartworm infection, which is likely related to this patient’s congestive heart failure.
Case 3: Prior History of Leukemia & Chemotherapy
Diagnosis: Acute lymphocytic leukemia (no longer in remission) with Babesia canis infection unmasked by immunosuppressive chemotherapy
Interpretation & DiscussionAlthough the total leukocyte count was within the reference interval, evaluation of leukocyte morphology in the blood film revealed that abnormal leukocytes, specifically large lymphoblasts, were the predominant cell type (Table 3). Once the blasts were included in the manual leukocyte differential as a separate category, the absolute counts of the other leukocyte types decreased.
Erythrocyte morphology was also abnormal. There were numerous intraerythrocytic piroplasms consistent with Babesia canis, which cannot be detected by hematology analyzers (Figure 13). In this case, the blood film contained important additional information that only a trained microscopist could discern during evaluation.

Did you answer…
The patient is out of remission since the predominant nucleated cell is the lymphoblast.
The automated leukocyte differential is not accurate since the blast cells were not reported by the analyzer.
The intraerythrocytic inclusions are presumably Babesia canis.
Figure 13: Figure 6 magnified to show intraerythrocytic piroplasms consistent with Babesia canis and a lymphoblast with a pale staining, oval nucleolus at the nuclear margin (right).